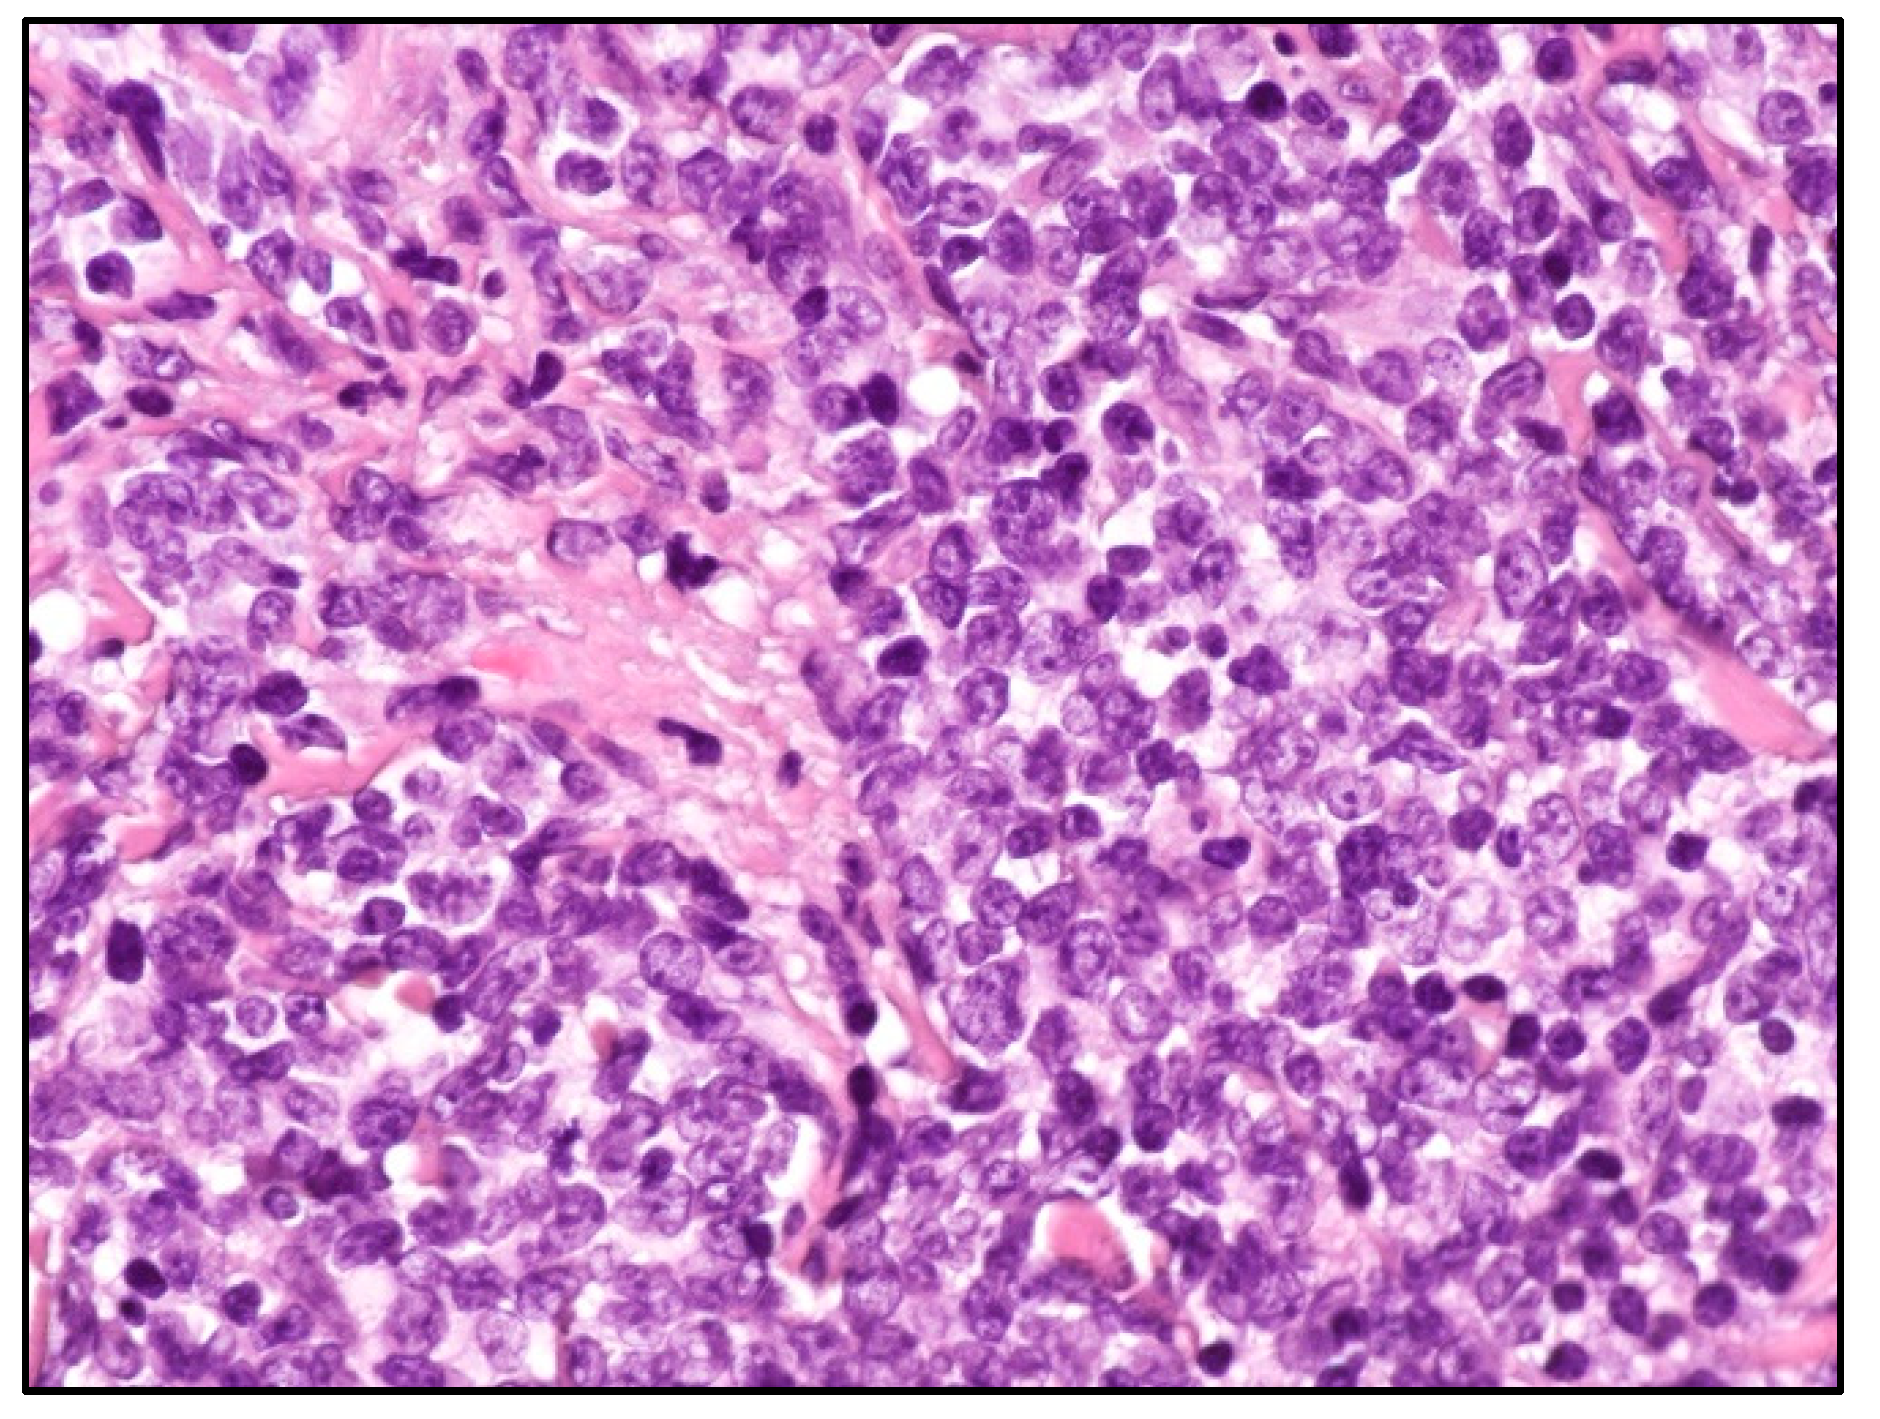
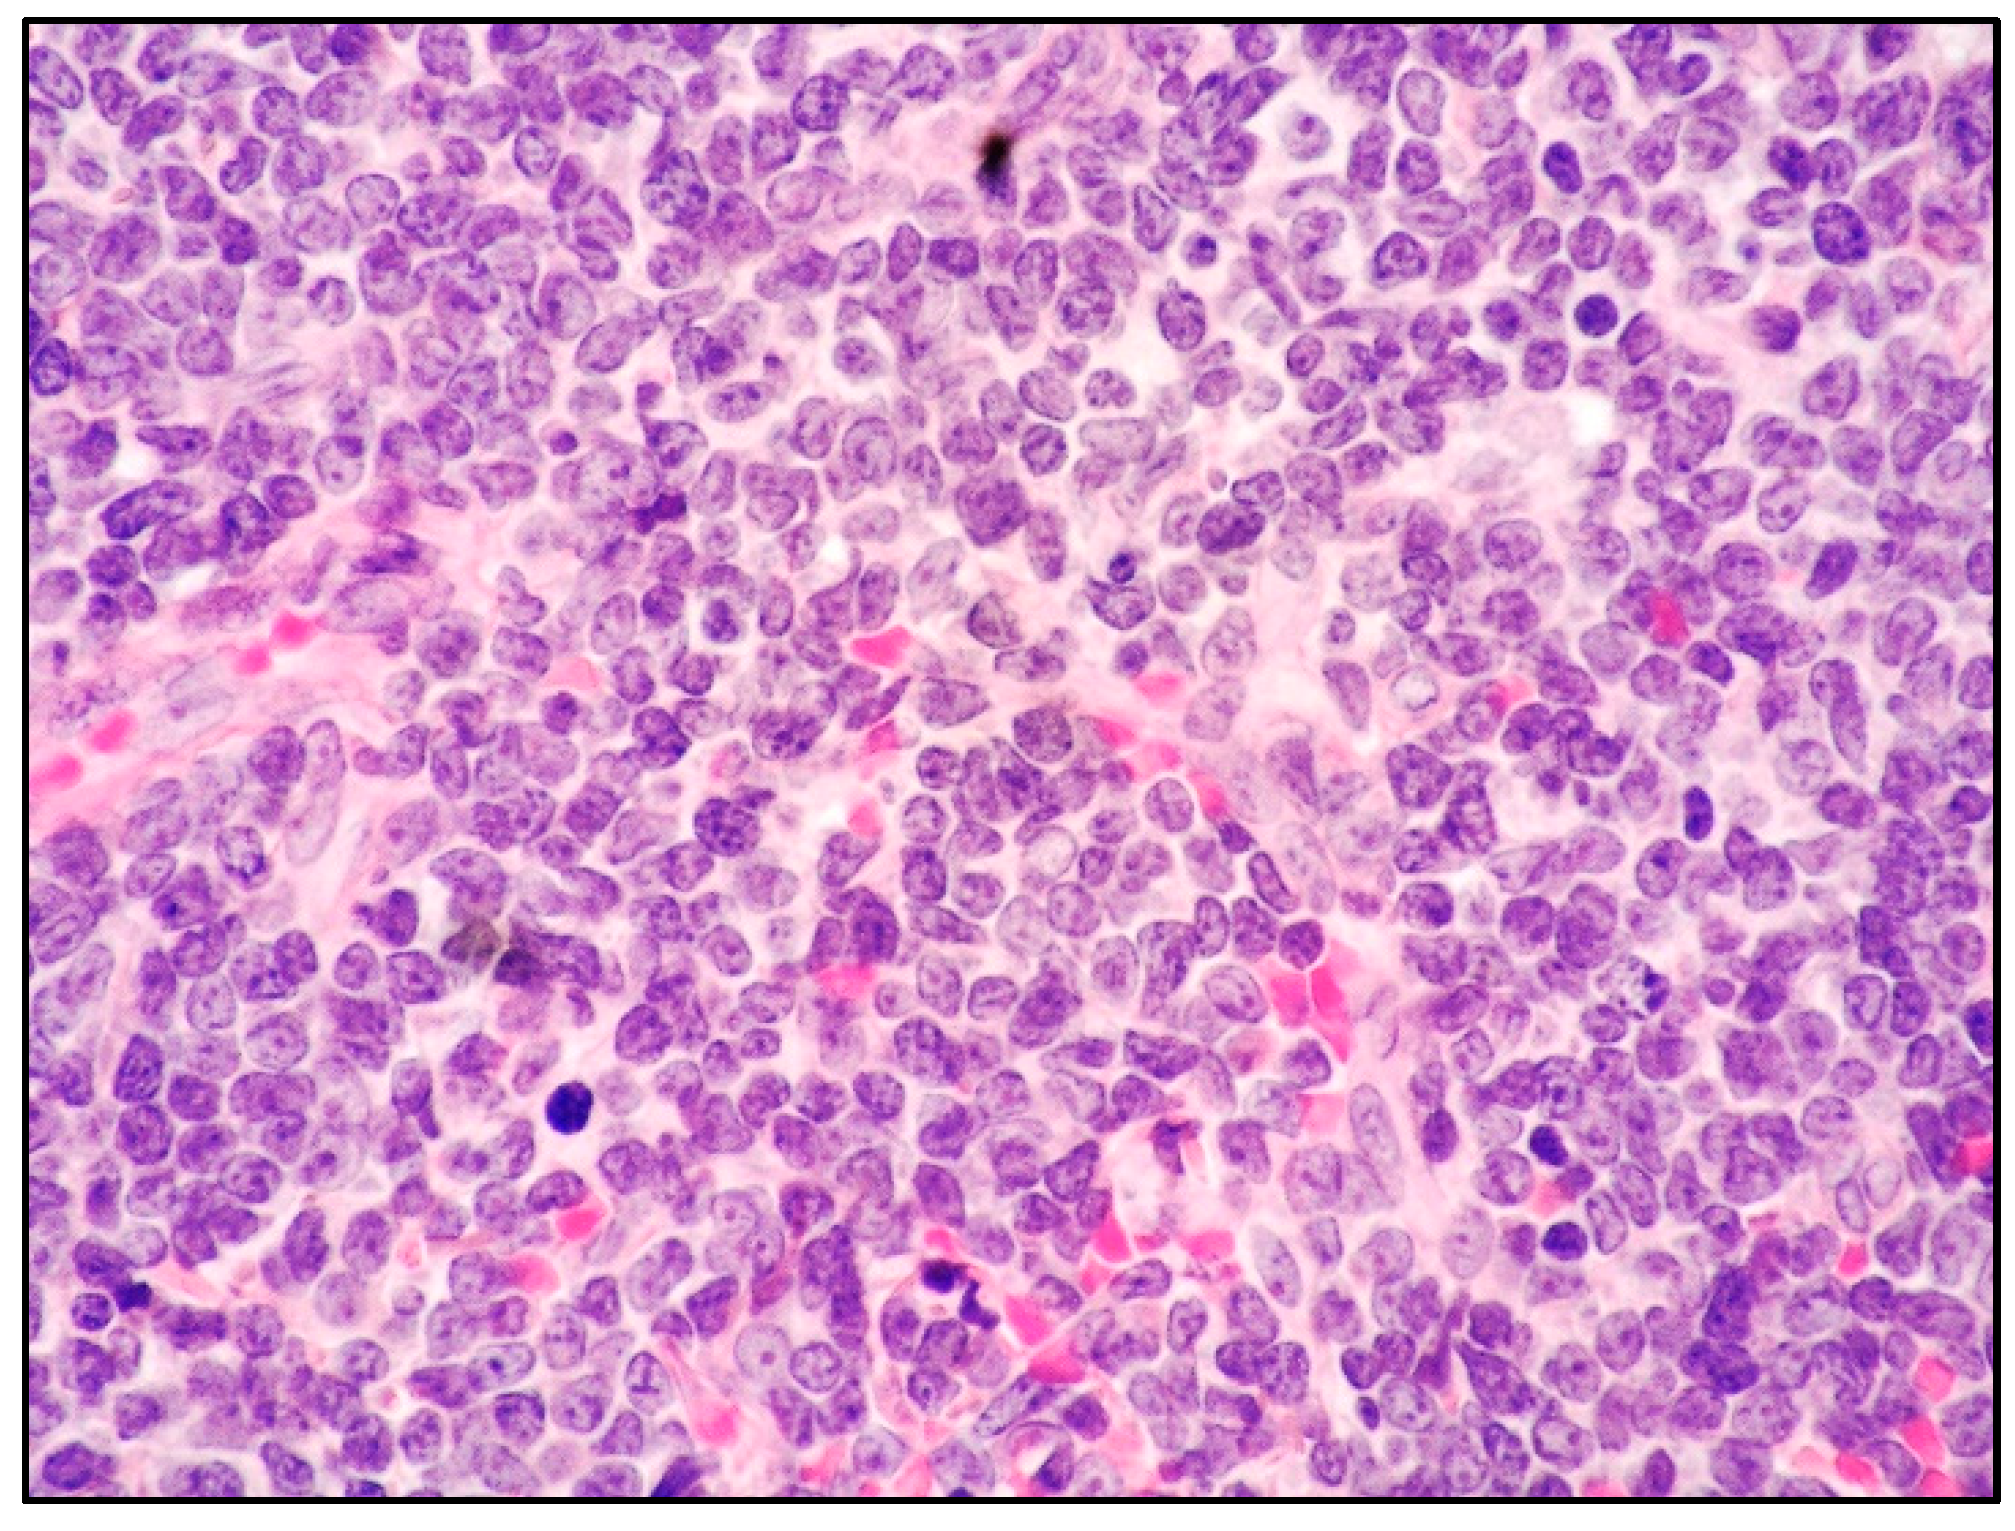

Skin Involvement by Hematological Neoplasms with Blastic Morphology: Lymphoblastic Lymphoma, Blastoid Variant of Mantle Cell Lymphoma and Differential Diagnoses
Abstract
Simple Summary
Abstract
1. Introduction
2. Mantle Cell Lymphoma (MCL): General Features
3. Histology, Cytological Variants, and Immunophenotypic Features of MCL
4. Blastoid MCL: General Features
5. MCL and Skin Involvement
6. Acute Lymphoblastic Leukemia/Lymphoma (ALL/LBL) of B- or T-Cell Origin
7. Histology and Immunophenotypic Features of B-LBL and T-LBL
8. LBL and Skin Involvement
9. A Focus on Other Hematological Neoplasms Sharing a Blastic Morphology and Presenting Cutaneous Involvement
10. Conclusions
Author Contributions
Funding
Acknowledgments
Conflicts of Interest
References
- Alaggio, R.; Amador, C.; Anagnostopoulos, I.; Attygalle, A.D.; Araujo, I.B.d.O.; Berti, E.; Bhagat, G.; Borges, A.M.; Boyer, D.; Calaminici, M.; et al. The 5th edition of the World Health Organization Classification of Haematolymphoid Tumours: Lymphoid Neoplasms. Leukemia 2022, 36, 1720–1748. [Google Scholar] [CrossRef] [PubMed]
- Campo, E.; Jaffe, E.S.; Cook, J.R.; Quintanilla-Martinez, L.; Swerdlow, S.H.; Anderson, K.C.; Brousset, P.; Cerroni, L.; de Leval, L.; Dirnhofer, S.; et al. The International Consensus Classification of Mature Lymphoid Neoplasms: A report from the Clinical Advisory Committee. Blood 2022, 140, 1229–1253. [Google Scholar] [CrossRef]
- Dreyling, M.; Klapper, W.; Rule, S. Blastoid and pleomorphic mantle cell lymphoma: Still a diagnostic and therapeutic challenge! Blood 2018, 132, 2722–2729. [Google Scholar] [CrossRef]
- Tieman, M.; Schrader, C.; Klapper, W.; Dreyling, M.H.; Campo, E.; Norton, A.; Berger, F.; Kluin, P.; Ott, G.; Pileri, S.; et al. Histopathology, cell proliferation indices and clinical outcome in 304 patients with mantle cell lymphoma (MCL): A clinicopathological study from the European MCL Network. Br. J. Haematol. 2005, 131, 29–38. [Google Scholar] [CrossRef] [PubMed]
- Foshat, M.; Stewart, J.; Khoury, J.D.; Staerkel, G.A.; Caraway, N.P. Accuracy of diagnosing mantle cell lymphoma and identifying its variants on fine-needle aspiration biopsy. Cancer Cytopathol. 2019, 127, 44–51. [Google Scholar] [CrossRef] [PubMed]
- Vogt, N.; Klapper, W. Variability in morphology and cell proliferation in sequential biopsies of mantle cell lymphoma at diagnosis and relapse: Clinical correlation and insights into disease progression. Histopathology 2013, 62, 334–342. [Google Scholar] [CrossRef]
- Sander, B.; Quintanilla-Martinez, L.; Ott, G.; Xerri, L.; Kuzu, I.; Chan, J.K.C.; Swerdlow, S.H.; Campo, E. Mantle cell lymphoma—A spectrum from indolent to aggressive disease. Virchows Arch. 2016, 468, 245–257. [Google Scholar] [CrossRef]
- Camacho, F.I.; García, J.F.; Cigudosa, J.C.; Mollejo, M.; Algara, P.; Ruíz-Ballesteros, E.; Gonzalvo, P.; Martín, P.; Pérez-Seoane, C.; Sánchez-García, J.; et al. Aberrant Bcl6 Protein Expression in Mantle Cell Lymphoma. Am. J. Surg. Pathol. 2004, 28, 1051–1056. [Google Scholar] [CrossRef]
- Challagundla, P.; Medeiros, L.J.; Kanagal-Shamanna, R.; Miranda, R.N.; Jorgensen, J.L. Differential expression of CD200 in B-cell neoplasms by flow cytometry can assist in diagnosis, subclassification, and bone marrow staging. Am. J. Clin. Pathol. 2014, 142, 837–844. [Google Scholar] [CrossRef]
- Mozos, A.; Royo, C.; Hartmann, E.; De Jong, D.; Baró, C.; Valera, A.; Fu, K.; Weisenburger, D.D.; Delabie, J.; Chuang, S.-S.; et al. SOX11 expression is highly specific for mantle cell lymphoma and identifies the cyclin D1-negative subtype. Haematologica 2009, 94, 1555–1562. [Google Scholar] [CrossRef]
- Lee, W.; Shin, E.; Kim, B.-H.; Kim, H. Diagnostic accuracy of SOX11 immunohistochemistry in mantle cell lymphoma: A meta-analysis. PLoS ONE 2019, 14, e0225096. [Google Scholar] [CrossRef] [PubMed]
- Dictor, M.; Ek, S.; Sundberg, M.; Warenholt, J.; Gyorgy, C.; Sernbo, S.; Gustavsson, E.; Abu-Alsoud, W.; Wadstrom, T.; Borrebaeck, C. Strong lymphoid nuclear expression of SOX11 transcription factor defines lymphoblastic neoplasms, mantle cell lymphoma and Burkitt’s lymphoma. Haematologica 2009, 94, 1563–1568. [Google Scholar] [CrossRef] [PubMed]
- Fu, K.; Weisenburger, D.D.; Greiner, T.C.; Dave, S.; Wright, G.; Rosenwald, A.; Chiorazzi, M.; Iqbal, J.; Gesk, S.; Siebert, R.; et al. Cyclin D1-negative mantle cell lymphoma: A clinicopathologic study based on gene expression profiling. Blood 2005, 106, 4315–4321. [Google Scholar] [CrossRef] [PubMed]
- Salaverria, I.; Royo, C.; Carvajal-Cuenca, A.; Clot, G.; Navarro, A.; Valera, A.; Song, J.Y.; Woroniecka, R.; Rymkiewicz, G.; Klapper, W.; et al. CCND2 rearrangements are the most frequent genetic events in cyclin D1− mantle cell lymphoma. Blood 2013, 121, 1394–1402. [Google Scholar] [CrossRef] [PubMed]
- Hoster, E.; Rosenwald, A.; Berger, F.; Bernd, H.W.; Hartmann, S.; Loddenkemper, C.; Barth, T.F.; Brousse, N.; Pileri, S.; Rymkiewicz, G.; et al. Faculty Prognostic Value of Ki-67 Index, Cytology, and Growth Pattern in Mantle-Cell Lymphoma: Results From Randomized Trials of the European Mantle Cell Lymphoma Network. J. Clin. Oncol. 2016, 34, 1386–1394. [Google Scholar] [CrossRef]
- Jain, P.; Wang, M. Blastoid Mantle Cell Lymphoma. Hematol. Oncol. Clin. N. Am. 2020, 34, 941–956. [Google Scholar] [CrossRef]
- Condoluci, A.; Rossi, D.; Zucca, E.; Cavalli, F. Toward a Risk-Tailored Therapeutic Policy in Mantle Cell Lymphoma. Curr. Oncol. Rep. 2018, 20, 79. [Google Scholar] [CrossRef]
- Aukema, S.M.; Hoster, E.; Rosenwald, A.; Canoni, D.; Delfau-Larue, M.-H.; Rymkiewicz, G.; Thorns, C.; Hartmann, S.; Kluin-Nelemans, H.; Hermine, O.; et al. Expression of TP53 is associated with the outcome of MCL independent of MIPI and Ki-67 in trials of the European MCL Network. Blood 2018, 131, 417–420. [Google Scholar] [CrossRef]
- Jain, P.; Zhang, S.; Kanagal-Shamanna, R.; Ok, C.Y.; Nomie, K.; Gonzalez, G.N.; Gonzalez-Pagan, O.; Hill, H.A.; Lee, H.J.; Fayad, L.; et al. Genomic profiles and clinical outcomes of de novo blastoid/pleomorphic MCL are distinct from those of transformed MCL. Blood Adv. 2020, 4, 1038–1050. [Google Scholar] [CrossRef]
- Bhatt, V.R.; Loberiza, F.R., Jr.; Smith, L.M. Clinicopathologic features, management and outcomes of blastoid variant of mantle cell lymphoma: A Nebraska Lymphoma Study Group Experience. Leuk. Lymphoma 2016, 57, 1327–1334. [Google Scholar] [CrossRef]
- Shrestha, R.; Bhatt, V.R.; Murthy, G.S.G.; Armitage, J.O. Clinicopathologic features and management of blastoid variant of mantle cell lymphoma. Leuk. Lymphoma 2015, 56, 2759–2767. [Google Scholar] [CrossRef] [PubMed]
- Pott, C.; Schrader, C.; Brüggemann, M.; Ritgen, M.; Harder, L.; Raff, T.; Tiemann, M.; Dreger, P.; Kneba, M. Blastoid variant of mantle cell lymphoma: Late progression from classical mantle cell lymphoma and quantitation of minimal residual disease. Eur. J. Haematol. 2005, 74, 353–358. [Google Scholar] [CrossRef] [PubMed]
- Kim, D.H.; Medeiros, L.J.; Aung, P.P.; Young, K.H.; Miranda, R.N.; Ok, C.Y. Mantle cell lymphoma involving skin: A clinicopathologic study of 37 cases. Am. J. Surg. Pathol. 2019, 43, 1421–1428. [Google Scholar] [CrossRef] [PubMed]
- Liu, Z.; Dong, H.Y.; Gorczyca, W.; Tsang, P.; Cohen, P.; Stephenson, C.F.; Berger, C.S.; Wu, C.D.; Weisberger, J. CD5-mantle cell lymphoma. Am. J. Clin. Pathol. 2002, 118, 216–224. [Google Scholar] [CrossRef][Green Version]
- Miao, Y.; Lin, P.; Saksena, A.; Xu, J.; Wang, M.; Romaguera, J.; Yin, C.C.; Medeiros, L.J.; Li, S. CD5-negative mantle cell lymphoma: Clinicopathologic correlations and outcome in 58 patients. Am. J. Surg. Pathol. 2019, 43, 1052–1060. [Google Scholar] [CrossRef]
- Zanetto, U.; Dong, H.; Huang, Y.; Zhang, K.; Narbaitz, M.; Sapia, S.; Kostopoulos, I.; Liu, H.; Du, M.-Q.; Bacon, C.M. Mantle cell lymphoma with aberrant expression of CD10. Histopathology 2008, 53, 20–29. [Google Scholar] [CrossRef]
- Hu, Z.; Medeiros, L.J.; Chen, Z.; Chen, W.; Li, S.; Konoplev, S.N.; Lu, X.; Pham, L.V.; Young, K.H.; Wang, W.; et al. Mantle cell lymphoma with MYC rearrangement: A report of 17 patients. Am. J. Surg. Pathol. 2017, 41, 216–224. [Google Scholar] [CrossRef]
- Sarkozy, C.; Terré, C.; Jardin, F.; Radford, I.; Roche-Lestienne, C.; Penther, D.; Bastard, C.; Rigaudeau, S.; Pilorge, S.; Morschhauser, F.; et al. Complex karyotype in mantle cell lymphoma is a strong prognostic factor for the time to treatment and overall survival, independent of the MCL international prognostic index. Genes Chromosom. Cancer 2014, 53, 106–116. [Google Scholar] [CrossRef]
- Jain, P.; Wang, M. Mantle cell lymphoma: 2019 update on the diagnosis, pathogenesis, prognostication, and management. Am. J. Hematol. 2019, 94, 710–725. [Google Scholar] [CrossRef]
- Wehkamp, U.; Pott, C.; Unterhalt, M.; Koch, K.; Weichenthal, M.; Klapper, W.; Oschlies, I. Skin involvement of mantle cell lymphoma may mimic primary cutaneous diffuse large B-cell lymphoma, leg type. Am. J. Surg. Pathol. 2015, 39, 1093–1101. [Google Scholar] [CrossRef][Green Version]
- Sen, F.; Medeiros, L.J.; Lu, D.; Jones, D.; Lai, R.; Katz, R.; Abruzzo, L.V. Mantle cell lymphoma involving skin: Cutaneous lesions may be the first manifestation of disease and tumors often have blastoid cytologic features. Am. J. Surg. Pathol. 2002, 26, 1312–1318. [Google Scholar] [CrossRef] [PubMed]
- Martí, R.M.; Campo, E.; Bosch, F.; Palou, J.; Estrach, T. Cutaneous lymphocyte-associated antigen (CLA) expression in a lymphoblastoid mantle cell lymphoma presenting with skin lesions. Comparison with other clinicopathologic presentations of mantle cell lymphoma. J. Cutan. Pathol. 2001, 28, 256–264. [Google Scholar] [CrossRef] [PubMed]
- Lynch, D.W.; Verma, R.; Larson, E.; Geis, M.C.; Jassim, A.D. Primary cutaneous mantle cell lymphoma with blastic features: Report of a rare case with special reference to staging and effectiveness of chemotherapy. J. Cutan. Pathol. 2012, 39, 449–453. [Google Scholar] [CrossRef] [PubMed]
- Canpolat, F.; Tas, E.; Sönmez, A.A.; Oktay, M.; Eskioglu, F.; Alper, M. Cutaneous presentation of mantle cell lymphoma. Acta Derm. Venereol. 2010, 90, 549–551. [Google Scholar] [CrossRef] [PubMed]
- Bertero, M.; Novelli, M.; Fierro, M.T.; Bernengo, M.G. Mantle zone lymphoma: An immunohistologic study of skin lesions. J. Am. Acad. Dermatol. 1994, 30, 23–30. [Google Scholar] [CrossRef]
- Alaibac, M.; Zattra, E.; Zambello, R.; Marino, F.; Bordignon, M. Primary Cutaneous Mantle Cell Lymphoma. Acta Derm. Venereol. 2011, 91, 474–475. [Google Scholar] [CrossRef]
- Mazzuoccolo, L.D.; Perez, G.A.C.; Sorin, I.; Bravo, A.I. Primary Cutaneous Mantle Cell Lymphoma: A Case Report. Case Rep. Dermatol. Med. 2013, 2013, 394596. [Google Scholar] [CrossRef][Green Version]
- Cesinaro, A.M.; Bettelli, S.; Maccio, L.; Milani, M. Primary cutaneous mantle cell lymphoma of the leg with blastoid morphology and aberrant immunophenotype: A diagnostic challenge. Am. J. Dermatopathol. 2014, 36, e16. [Google Scholar] [CrossRef]
- Gru, A.A.; Hurley, M.Y.; Salavaggione, A.L.; Brodell, L.; Sheinbein, D.; Anadkat, M.; Porcu, P.; Frater, J.L. Cutaneous mantle cell lymphoma: A clinicopathologic review of 10 cases. J. Cutan. Pathol. 2016, 43, 1112–1120. [Google Scholar] [CrossRef]
- Panse, G.; Cowper, S.; Ko, C.J.; Subtil, A. Cutaneous Involvement by Mantle Cell Lymphoma: Expanding the Spectrum of Histopathologic Findings in a Series of 9 Cases. Am. J. Dermatopathol. 2020, 42, 848–853. [Google Scholar] [CrossRef]
- Estrozi, B.; Sanches, J.A., Jr.; Varela, P.C.; Bacchi, C.E. Primary cutaneous blastoid mantle cell lymphoma-case report. Am. J. Dermatopathol. 2009, 31, 398–400. [Google Scholar] [CrossRef] [PubMed]
- Hamad, N.; Armytage, T.; McIlroy, K.; Singh, N.; Ward, C. Primary Cutaneous Mantle-Cell Lymphoma: A Case Report and Literature Review. J. Clin. Oncol. 2015, 33, e104–e108. [Google Scholar] [CrossRef] [PubMed]
- Samra, B.; Jabbour, E.; Ravandi, F.; Kantarjian, H.; Short, N.J. Evolving therapy of adult acute lymphoblastic leukemia: State-of-the-art treatment and future directions. J. Hematol. Oncol. 2020, 13, 70. [Google Scholar] [CrossRef]
- Dunsmore, K.P.; Winter, S.S.; Devidas, M.; Wood, B.L.; Esiashvili, N.; Chen, Z.; Eisenberg, N.; Briegel, N.; Hayashi, R.J.; Gastier-Foster, J.M.; et al. Children’s Oncology Group AALL0434: A Phase III Randomized Clinical Trial Testing Nelarabine in Newly Diagnosed T-Cell Acute Lymphoblastic Leukemia. J. Clin. Oncol. 2020, 38, 3282–3293. [Google Scholar] [CrossRef] [PubMed]
- Hashimoto, M.; Yamashita, Y.; Mori, N. Immunohistochemical detection of CD79a expression in precursor T cell lymphoblastic lymphoma/leukaemias. J. Pathol. 2002, 197, 341–347. [Google Scholar] [CrossRef]
- Patel, J.L.; Smith, L.M.; Anderson, J.; Abromowitch, M.; Campana, D.; Jacobsen, J.; Lones, M.A.; Gross, T.G.; Cairo, M.S.; Perkins, S.L. The immunophenotype of T-lymphoblastic lymphoma in children and adolescents: A Children’s Oncology Group report. Br. J. Haematol. 2012, 159, 454–461. [Google Scholar] [CrossRef] [PubMed]
- Zanelli, M.; Loscocco, G.G.; Sabattini, E.; Zizzo, M.; Sanguedolce, F.; Panico, L.; Fanni, D.; Santi, R.; Caprera, C.; Rossi, C.; et al. T-Cell Lymphoblastic Lymphoma Arising in the Setting of Myeloid/Lymphoid Neoplasms with Eosinophilia: LMO2 Immunohistochemistry as a Potentially Useful Diagnostic Marker. Cancers 2021, 13, 3102. [Google Scholar] [CrossRef]
- Lee, W.J.; Moon, H.R.; Won, C.H.; Chang, S.E.; Choi, J.H.; Moon, K.C.; Lee, M.W. Precursor B- or T-lymphoblastic lymphoma presenting with cutaneous involvement: A series of 13 cases including 7 cases of cutaneous T-lymphoblastic lymphoma. J. Am. Acad. Dermatol. 2014, 70, 318–325. [Google Scholar] [CrossRef]
- Chou, Y.-C.; Shih, I.-H.; Yang, C.-P.; Kuo, T.-T.; Hong, H.-S. Concurrent Mycosis Fungoides and Precursor B Cell Lymphoblastic Lymphoma in a 6-Year-Old Child. Pediatr. Dermatol. 2005, 22, 23–25. [Google Scholar] [CrossRef]
- Nagasaki, A.; Miyagi, T.; Nakazato, T.; Taira, N.; Ohshima, K.; Kikuchi, M.; Takasu, N.; Masauda, M. Very Late Central Nervous System Relapse in a Patient with B Cell Lymphoblastic Lymphoma. Acta Haematol. 2004, 112, 212–216. [Google Scholar] [CrossRef]
- Hsiao, C.-H.; Su, I.-J. Primary cutaneous pre-B lymphoblastic lymphoma immunohistologically mimics Ewing’s sarcoma/primitive neuroectodermal tumor. J. Formos. Med. Assoc. 2003, 102, 193–197. [Google Scholar]
- Kahwash, S.; Qualman, S.J. Cutaneous Lymphoblastic Lymphoma in Children: Report of Six Cases with Precursor B-cell Lineage. Pediatr. Dev. Pathol. 2002, 5, 45–53. [Google Scholar] [CrossRef]
- Maitra, A.; McKenna, R.W.; Weinberg, A.G.; Schneider, N.R.; Kroft, S.H. Precursor B-cell lymphoblastic lymphoma: A study of nine cases lacking blood and bone marrow involvement and review of the literature. Am. J. Clin. Pathol. 2001, 115, 868–875. [Google Scholar] [CrossRef] [PubMed]
- Lin, P.; Jones, D.; Dorfman, D.M.; Medeiros, L.J. Precursor B-cell lymphoblastic lymphoma: A predominantly extranodal tumor with low propensity for leukemic involvement. Am. J. Surg. Pathol. 2000, 24, 1480–1490. [Google Scholar] [CrossRef] [PubMed]
- Chimenti, S.; Fink-Puches, R.; Peris, K.; Pescarmona, E.; Putz, B.; Kerl, H.; Cerroni, L. Cutaneous involvement in lymphoblastic lymphoma. J. Cutan. Pathol. 1999, 26, 379–385. [Google Scholar] [CrossRef]
- Millot, F.; Robert, A.; Bertrand, Y.; Mechinaud, F.; Laureys, G.; Ferster, A.; Brock, P.; Rohrlich, P.; Mazingue, F.; Plantaz, D.; et al. Cutaneous involvement in children with acute lymphoblastic leukemia or lymphoblastic lymphoma: The children’s leukemia cooperative group of the European Organization of Research and Treatment of Cancer (EORTC). Pediatrics 1997, 100, 60–64. [Google Scholar] [CrossRef]
- Schmitt, I.; Manente, L.; Di Matteo, A.; Felici, F.; Giangiacomi, M.; Chimenti, S. Lymphoblastic Lymphoma of the Pre-B Phenotype with Cutaneous Presentation. Dermatology 1997, 195, 289–292. [Google Scholar] [CrossRef] [PubMed]
- Sander, C.A.; Medeiros, L.J.; Abruzzo, L.V.; Horak, I.D.; Jaffe, E.S. Lymphoblastic lymphoma presenting in cutaneous sites: A clinicopathologic analysis of six cases. J. Am. Acad. Dermatol. 1991, 25, 1023–1031. [Google Scholar] [CrossRef] [PubMed]
- Grümayer, E.R.; Ladenstein, R.L.; Gadner, H.; Slavc, I.; Urban, C.; Radaszkiewicz, T.; Bettelheim, P. B-cell differentiation pattern of cutaneous lymphomas in infancy and childhood. Cancer 1988, 61, 303–308. [Google Scholar] [CrossRef]
- Link, M.P.; Roper, M.; Dorfman, R.F.; Crist, W.M.; Cooper, M.D.; Levy, R. Cutaneous lymphoblastic lymphoma with pre-B markers. Blood 1983, 61, 838–841. [Google Scholar] [CrossRef]
- Meyers, L.; Hakami, N. Pre-B cell cutaneous lymphoma in infancy: A unique clinical entity. Med. Pediatr. Oncol. 1984, 12, 252–254. [Google Scholar] [CrossRef]
- Bernard, A.; Murphy, S.B.; Melvin, S.; Bowman, W.P.; Caillaud, J.; Lemerle, J.; Boumsell, L. Non-T, non-B lymphomas are rare in childhood and associated with cutaneous tumor. Blood 1982, 59, 549–554. [Google Scholar] [CrossRef]
- Biasotti, S.; Sementa, A.R.; Zupo, S.; Nemelka, O.; Pistoia, V.; Garaventa, A. A novel pediatric case of cutaneous pre-B lymphoblastic lymphoma. Haematologica 2001, 86, 997–998. [Google Scholar] [PubMed]
- Wood, G.S.; Burke, J.S.; Horning, S.; Doggett, R.S.; Levy, R.; Warnke, R.A. The immunologic and clinicopathologic heterogeneity of cutaneous lymphomas other than mycosis fungoides. Blood 1983, 62, 464–472. [Google Scholar] [CrossRef]
- Trupiano, J.K.; Bringelsen, K.; Hsi, E.D. Primary cutaneous lymphoblastic lymphoma presenting in an 8-week old infant. J. Cutan. Pathol. 2002, 29, 107–112. [Google Scholar] [CrossRef] [PubMed]
- Muljono, A.; Nicole, S.; Arbuckle, G. Primary cutaneous lymphoblastic lymphoma in children: Series of eight cases with review of the literature. Pathology 2009, 41, 223–228. [Google Scholar] [CrossRef] [PubMed]
- Kawakami, T.; Kimura, S.; Kinoshita, A.; Kondo, K.; Soma, Y. Precursor B-cell Lymphoblastic Lymphoma with only Cutaneous Involvement. Acta Derm. Venereol. 2009, 89, 540–541. [Google Scholar] [CrossRef] [PubMed]
- Amarasekera, D.; Connolly, D.; Gochoco, A.; Yang, S.; Grosso, D.; Flomenberg, N.; Shi, W.; Alpdogan, S.O.; Duffy, R.; Sahu, J. Cutaneous B-Cell Lymphoblastic Lymphoma. Am. J. Dermatopathol. 2019, 41, 596–601. [Google Scholar] [CrossRef]
- Boccara, O.; Laloum-Grynberg, E.; Jeudy, G.; Aubriot-Lorton, M.-H.; Vabres, P.; de Prost, Y.; Pacquement, H.; Brousse, N.; Fraitag, S.; Bodemer, C. Cutaneous B-cell lymphoblastic lymphoma in children: A rare diagnosis. J. Am. Acad. Dermatol. 2012, 66, 51–57. [Google Scholar] [CrossRef]
- Ducassou, S.; Ferlay, C.; Bergeron, C.; Girard, S.; Laureys, G.; Pacquement, H.; Plantaz, D.; Lutz, P.; Vannier, J.P.; Uyttebroeck, A.; et al. Clinical presen- tation, evolution, and prognosis of precursor B-cell lym- phoblastic lymphoma in trials LMT96, EORTC 58881, and EORTC 58951. Br. J. Haematol. 2011, 152, 441–451. [Google Scholar] [CrossRef]
- Gupta, R.; Borkataky, S.; Aggarwal, D.; Singh, S.; Gupta, K.; Kudesia, M. Primary cutaneous B-cell lymphoblastic lymphoma. Indian J. Dermatol. Venereol. Leprol. 2008, 74, 652–654. [Google Scholar] [CrossRef] [PubMed]
- Rashidghamat, E.; Robson, A. Primary cutaneous pre- cursor B cell lymphoblastic lymphoma in a child, complicated by fatal disseminated varicella zoster virus. Clin. Exp. Dermatol. 2015, 40, 839–843. [Google Scholar] [CrossRef] [PubMed]
- Song, H.; Todd, P.; Chiarle, R.; Billett, A.L.; Gellis, S. Primary Cutaneous B-Cell Lymphoblastic Lymphoma Arising from a Long-Standing Lesion in a Child and Review of the Literature. Pediatr. Dermatol. 2017, 34, e182–e186. [Google Scholar] [CrossRef]
- Fink-Puches, R.; Chott, A.; Ardigo, M.; Simonitsch, I.; Ferrara, G.; Kerl, H.; Cerroni, L. The Spectrum of Cutaneous Lymphomas in Patients Less than 20 Years of Age. Pediatr. Dermatol. 2004, 21, 525–533. [Google Scholar] [CrossRef]
- Gallagher, G.; Chhanabhai, M.; Song, K.W.; Barnett, M.J. Unusual presentation of precursor T-cell lymphoblastic lymphoma: Involvement limited to breasts and skin. Leuk. Lymphoma 2007, 48, 428–430. [Google Scholar] [CrossRef] [PubMed]
- Prasad, P.G.; Cyriac, S.; Sagar, T.G.; Rathnam, K. T lymphoblastic lymphoma relapsing in skin—A rare clinical scenario. Indian J. Hematol. Blood Transfus. 2010, 26, 19–20. [Google Scholar] [CrossRef][Green Version]
- Vezzoli, P.; Novara, F.; Fanoni, D.; Gambini, D.; Balice, Y.; Venegoni, L.; Paulli, M.; Crosti, C.; Berti, E. Three cases of primary cutaneous lymphoblastic lymphoma: Microarray-based comparative genomic hybridization and gene expression profiling studies with review of literature. Leuk. Lymphoma 2012, 53, 1978–1987. [Google Scholar] [CrossRef]
- Nascimbeni, C.; Chantepie, S.; Brugiere, C.; Comoz, F.; Salaun, V.; Verneuil, L. Cutaneous involvement in T-lymphoblastic lymphoma. Ann. Dermatol. Venereol. 2017, 144, 268–274. [Google Scholar] [CrossRef]
- Montes-Torres, A.; Llamas-Velasco, M.; Capusan, T.M.; Aguado, B.; Adrados, M. Cutaneous involvement as the first manifestation of T-lymphoblastic lymphoma and review of the literature. J. Cutan. Pathol. 2019, 46, 372–375. [Google Scholar] [CrossRef]
- Zanelli, M.; Zizzo, M.; Martino, G.; Sanguedolce, F.; Ascani, S. Erythematous cutaneous macules: An uncommon, challenging presentation of T-lymphoblastic lymphoma. Eur. J. Dermatol. 2020, 30, 318–320. [Google Scholar] [CrossRef]
- Bassan, R.; Bourquin, J.-P.; DeAngelo, D.J.; Chiaretti, S. New Approaches to the Management of Adult Acute Lymphoblastic Leukemia. J. Clin. Oncol. 2018, 36, 3504–3519. [Google Scholar] [CrossRef] [PubMed]
- Bontoux, C.; De Masson, A.; Boccara, O.; Bodemer, C.; Fraitag, S.; Balme, B.; Franck, N.; Carlotti, A.; Comoz, F.; Verneuil, L.; et al. Outcome and clinicophenotypical features of acute lymphoblastic leukemia/lymphoblastic lymphoma with cutaneous involvement: A multicenter case series. J. Am. Acad. Dermatol. 2020, 83, 1166–1170. [Google Scholar] [CrossRef]
- Kallen, M.E.; Rao, N.P.; Kulkarni, S.K.; Pullarkat, S.T.; Said, J.; Tirado, C.A.; Ahmed, R.S.; Miller, J.M.; Chung, P.Y.; Kahn, D.G.; et al. B-lymphoblastic transformation of mantle cell lymphoma/leukemia with “double hit” changes. J. Hematopath. 2015, 8, 31–36. [Google Scholar] [CrossRef]
- Cantu, D.; Alvarado, Y.; Murata-Collins, J.; Weisenburger, D.D. Blastic transformation of mantle cell lymphoma with B-lymphoblastic features. Hum. Pathol. Case Rep. 2019, 17, 200313. [Google Scholar] [CrossRef]
- Aukema, S.M.; Croci, G.A.; Bens, S.; Oehl-Huber, K.; Wagener, R.; Ott, G.; Rosenwald, A.; Kluin, P.M.; Berg, E.V.D.; Bosga-Bouwer, A.G.; et al. Mantle cell lymphomas with concomitant MYC and CCND1 breakpoints are recurrently TdT positive and frequently show high-grade pathological and genetic features. Virchows Arch. 2021, 479, 133–145. [Google Scholar] [CrossRef] [PubMed]
- Cerroni, L. Skin Lymphoma: The illustrated Guide, 5th ed.; Wiley-Backwell: Hoboken, NJ, USA, 2020. [Google Scholar]
- Ok, C.Y.; Xu-Monette, Z.Y.; Tzankov, A.; O’Malley, D.P.; Montes-Moreno, S.; Visco, C.; Møller, M.B.; Dybkaer, K.; Orazi, A.; Zu, Y.; et al. Prevalence and clinical implications of cyclin D1 expression in diffuse large B-cell lymphoma (DLBCL) treated with immunochemotherapy: A report from the International DLBCL Rituximab-CHOP Consortium Program. Cancer 2014, 120, 1818–1829. [Google Scholar] [CrossRef]
- Zanelli, M.; Palicelli, A.; Sanguedolce, F.; Zizzo, M.; Filosa, A.; Ricci, L.; Cresta, C.; Martino, G.; Bisagni, A.; Zanetti, E.; et al. Cutaneous Involvement in Diseases with Plasma Cell Differentiation: Diagnostic Approach. Curr. Oncol. 2022, 29, 3026–3043. [Google Scholar] [CrossRef]
- Bhutani, M.; Shahid, Z.; Schnebelen, A.; Alapat, D.; Usmani, S.Z. Cutaneous manifestations of multiple myeloma and other plasma cell proliferative disorders. Semin. Oncol. 2016, 43, 395–400. [Google Scholar] [CrossRef]
- Kois, J.M.; Sexton, F.M.; Lookingbill, D.P. Cutaneous Manifestations of Multiple Myeloma. Arch. Dermatol. 1991, 127, 69–74. [Google Scholar] [CrossRef]
- Requena, L.; Kutzer, H.; Palmedo, G.; Calonje, E.; Requena, C.; Perez, G.; Pastor, M.A.; Sangueza, O.P. Cutaneous involvement in multiple myeloma. A clinicopathologic, immunohistochemical ad cytogenetic study of 8 cases. Arch. Dermatol. 2003, 139, 475–486. [Google Scholar] [CrossRef]
- Woo, Y.R.; Kim, J.S.; Lim, J.H.; Hwang, S.; Kim, M.; Bae, J.M.; Park, Y.M.; Min, C.-K.; Kim, D.-W.; Park, H.J. Prevalence and clinicopathologic characteristics of multiple myeloma with cutaneous involvement: A case series from Korea. J. Am. Acad. Dermatol. 2018, 78, 471–478.e4. [Google Scholar] [CrossRef]
- Jurczyszyn, A.; Olszewska-Szopa, M.; Hungria, V.; Crusoe, E.; Pika, T.; Delforge, M.; Leleu, X.; Rasche, L.; Nooka, A.K.; Druzd-Sitek, A.; et al. Cutaneous involvement in multiple myeloma: A multi-institutional retrospective study of 53 patients. Leuk. Lymphoma 2016, 57, 2071–2076. [Google Scholar] [CrossRef] [PubMed]
- Malysz, J.; Talamo, G.; Zhu, J.; Clarke, L.E.; Bayerl, M.G.; Ali, L.; Helm, K.F.; Chung, C.G. Cutaneous involvement in multiple myeloma (MM): A case series with clinicopathologic correlation. J. Am. Acad. Dermatol. 2016, 74, 878–884. [Google Scholar] [CrossRef]
- Marchica, V.; Accardi, F.; Storti, P.; Mancini, C.; Martella, E.; Dalla Palma, B.; Bolzoni, M.; Todoerti, K.; Marcatti, M.; Schifano, C.; et al. Cutaneous localization in multiple myeloma in the context of bortezomib-based treatment: How do myeloma cells escape from the bone marrow to the skin? Int. J. Hematol. 2017, 105, 104–108. [Google Scholar] [CrossRef]
- Varricchio, S.; Pagliuca, F.; Travaglino, A.; Gallo, L.; Villa, M.R.; Mascolo, M. Cutaneous localization of plasmablastic multiple myeloma with heterotopic expression of CD3 and CD4: Skin involvement revealing systemic disease. J. Cutan. Pathol. 2019, 46, 619–622. [Google Scholar] [CrossRef] [PubMed]
- Delecluse, H.; Anagnostopoulos, I.; Dallenbach, F.E.; Hummel, M.; Marafioti, T.; Schneider, U.; Huhn, D.; Schmidt-Westhausen, A.; Reichart, P.A.; Gross, U.; et al. Plasmablastic lymphomas of the oral cavity: A new entity associated with the human immunodeficiency virus infection. Blood 1997, 89, 1413–1420. [Google Scholar] [CrossRef] [PubMed]
- Zizzo, M.; Zanelli, M.; Martiniani, R.; Sanguedolce, F.; De Marco, L.; Martino, G.; Parente, P.; Annessi, V.; Manzini, L.; Ascani, S. Oral plasmablastic lymphoma: A case report. Medicine 2020, 99, e22335. [Google Scholar] [CrossRef]
- Castillo, J.J.; Bibas, M.; Miranda, R.N. The biology and treatment of plasmablastic lymphoma. Blood 2015, 125, 2323–2330. [Google Scholar] [CrossRef]
- Morscio, J.; Dierickx, D.; Nijs, J.; Verhoef, G.; Bittoun, E.; Vanoeteren, X.; Wlodarska, I.; Sagaert, X.; Tousseyn, T. Clinicopathologic comparison of plasmablastic lymphoma in HIV-positive, immunocompetent and posttransplant patients single-center series of 25 cases and meta-analysis of 277 reported cases. Am. J. Surg. Pathol. 2014, 38, 875–886. [Google Scholar] [CrossRef]
- Harmon, C.M.; Smith, L.B. Plasmablastic Lymphoma: A Review of Clinicopathologic Features and Differential Diagnosis. Arch. Pathol. Lab. Med. 2016, 140, 1074–1078. [Google Scholar] [CrossRef]
- Zanelli, M.; Sanguedolce, F.; Palicelli, A.; Zizzo, M.; Martino, G.; Caprera, C.; Fragliasso, V.; Soriano, A.; Valle, L.; Ricci, S.; et al. EBV-driven lymphoproliferative disorders and lymphomas of the gastrointestinal tract: A spectrum of entities with a common denominator (Part 2). Cancers 2021, 13, 4527. [Google Scholar] [CrossRef] [PubMed]
- Sanguedolce, F.; Zanelli, M.; Zizzo, M.; Martino, G.; Rossi, C.; Parente, P.; Ascani, S. Clinical, pathological and molecular features of plasmablastic lymphoma arising in the gastrointestinal tract: A review and reappraisal. Pathol. Res. Pract. 2020, 216, 152973. [Google Scholar] [CrossRef] [PubMed]
- Lopez, A.; Abrisqueta, P. Plasmablastic lymphoma: Current perspectives. Blood Lymphat. Cancer: Targets Ther. 2018, 8, 63–70. [Google Scholar] [CrossRef]
- Jordan, L.B.; Lessells, A.M.; Goodlad, J.R. Plasmablastic lymphoma arising at a cutaneous site. Histopathology 2005, 46, 113–115. [Google Scholar] [CrossRef]
- Heiser, D.; Müller, H.; Kempf, W.; Eisendle, K.; Zelger, B. Primary cutaneous plasmablastic lymphoma of the lower leg in an HIV-negative patient. J. Am. Acad. Dermatol. 2012, 67, e202–e205. [Google Scholar] [CrossRef]
- Jambusaria, A.; Shafer, D.; Wu, H.; Al-Saleem, T.; Perlis, C. Cutaneous plasmablastic lymphoma. J. Am. Acad. Dermatol. 2008, 58, 676–678. [Google Scholar] [CrossRef]
- Tiong, I.S.; Strauss, M.; Lau, M.B.; Chiruka, S. Cutaneous plasmablastic lymphoma in an immunocompetent patient with long-term pyrimethamine use for essential thrombocytemia: A case report and literature review. Case Rep. Hematol. 2013, 2013, 541783. [Google Scholar] [PubMed]
- Kaur, V.; Swami, A.; Alapat, D.; Abdallah, A.O.; Motwani, P.; Hutchins, L.F.; Jethava, Y. Clinical characteristics, molecular profile and outcomes of myeloid sarcoma: A single institution experience over 13 years. Hematology 2018, 23, 17–24. [Google Scholar] [CrossRef] [PubMed]
- Loscocco, G.G.; Vannucchi, A.M. Myeloid sarcoma: More and less than a distinct entity. Ann. Hematol. 2023, 102, 1973–1984. [Google Scholar] [CrossRef]
- Alexiev, B.A.; Wang, W.; Ning, Y.; Chumsri, S.; Gojo, I.; Rodgers, W.H.; Stass, S.A.; Zhao, X.F. Myeloid sarcomas: A histologic, immunohistochemical, and cytogenetic study. Diagn. Pathol. 2007, 2, 42. [Google Scholar] [CrossRef]
- Pileri, S.A.; Ascani, S.; Cox, M.C.; Campidelli, C.; Bacci, F.; Piccioli, M.; Piccaluga, P.P.; Agostinelli, C.; Asioli, S.; Novero, D.; et al. Myeloid sarcoma: Clinico-pathologic, phenotypic and cytogenetic analysis of 92 adult patients. Leukemia 2007, 21, 340–350. [Google Scholar] [CrossRef] [PubMed]
- Laribi, K.; De Materre, A.B.; Sobh, M.; Cerroni, L.; Valentini, C.G.; Aoki, T.; Suzuki, R.; Takeuchi, K.; Frankel, A.E.; Cota, C.; et al. Blastic plasmacytoid dendritic cell neoplasms: Results of an international survey on 398 adult patients. Blood Adv. 2020, 4, 4838–4848. [Google Scholar] [CrossRef] [PubMed]
- Jegalian, A.G.; Buxbaum, N.P.; Facchetti, F.; Raffeld, M.; Pittaluga, S.; Wayne, A.S.; Jaffe, E.S. Blastic plasmacytoid dendritic cell neoplasm in children: Diagnostic features and clinical implications. Haematologica 2010, 95, 1873–1879. [Google Scholar] [CrossRef] [PubMed]
- Liao, C.; Hu, N.-X.; Song, H.; Zhang, J.-Y.; Shen, D.-Y.; Xu, X.-J.; Tang, Y.-M. Pediatric blastic plasmacytoid dendritic cell neoplasm: Report of four cases and review of literature. Int. J. Hematol. 2021, 113, 751–759. [Google Scholar] [CrossRef] [PubMed]
- Loscocco, G.G.; Piccini, M.; Vergoni, F.; Vannucchi, A.M.; Bosi, A. A case of disseminated blastic plasmocytoid dendritic cell neoplasm. Am. J. Hematol. 2018, 93, 1433–1434. [Google Scholar] [CrossRef]

| Sex/Age | Cutaneous Manifestations | Histology | Cell of Origin | IHC | Outcome | |
|---|---|---|---|---|---|---|
| Blastoid MCL | M:F = 3:1; late sixties | Solitary/multiple papules or nodules; often on extremities. Often previous history of MCL; skin lesions in recurrent and progressive disease | Diffuse dermal and subcutaneous tissue infiltrate; no epidermis and Grenz zone involvement. Monomorphic, medium-sized cells, round/oval nuclei, dispersed chromatin, inconspicuous nucleolus | Mature, naïve B-lymphocytes | CD20+, cyclin D1+, TdT−, CD3−, CD5+ (CD5 loss in 25-28% of blastoid MCL); aberrant expression of CD10, BCL6, CD23; TP53 overexpressed; high Ki67 | Poor. Intensive CT and immunotherapy plus ASCT; recently, anti CD19 CART cells, venetoclax, ibrutinib, acalabrutinib |
| B-LBL | F:M = 2:1 children young adults | Often solitary, firm papule or nodule on head and neck. Skin lesions in 15-33% of B-LBL; skin lesions associated with systemic disease | Dense dermal infiltrate; no epidermis and Grenz zone involvement; uniform, small, medium-sized cells, round/oval/convoluted nuclei, fine chromatin, barely visible nucleoli, scarce basophilic cytoplasm; numerous mitoses | Precursor B- lymphocytes | TdT+, CD34+, CD10+, PAX5+, cCD79alpha+, CD19+, CD22+, high Ki67 | Good prognosis in 70% of cases with B-lineage ALL-type. Multiagent CT. |
| T-LBL | M:F = 3:1 children young adults | Multiple papules or nodules on head and neck (83.3%); different anatomic areas in 41.7%. Skin lesions rare in T-LBL (4.3% of cases); skin lesions secondary to T-LBL in mediastinum or lymph nodes | Histology identical to B-LBL | Precursor T-lymphocytes | TdT+, CD34+, CD1a+, CD99+, CD117+, cCD3+, sCD3+, CD2+, CD5+, CD7+, aberrant cCD79alpha+, aberrant myeloid markers+ | Cutaneous T-LBL are rare, but with a worse outcome compared to cutaneous B-LBL despite multiagent CT. |
| MS | Any age | Localized or generalized violaceus papules, plaques, nodules. Cutaneous MS often in patients with antecedent AML (55–77%) on BM; in 23–44% of cases, cutaneous MS appears at the initial presentation of AML (23–44%) or precedes AML (2–3%). | Dense dermal and subcutaneous tissue infiltrate with sparing of the upper papillary dermis and epidermis. Single cell filing pattern with single files of cells between collagen bundles. Cells with myelomonocytic features or more immature cells with blastic morphology. | Myeloid precursors | Phenotype depends on the subtype of AML (CD34+/−, CD117+/−, TdT+/−, MPO+, CD15+); CD4 and CD56 may be+; CD43 often+; lysozyme often+; NPM1+ in 30% of AML with normal karyotype. | Poor despite intensive CT+ HSCT AML without skin involvement: 30% 2 year survival. AML with skin involvement: 6% 2 year survival. |
| BPDCN | Adults, elderly. Rare in children | Solitary, localized, or generalized brown plaques or nodules. The skin is often the primary site of disease, rapidly followed by leukemic spread. | Diffuse dermal and subcutaneous tissue infiltrate of monomorphic small to medium-sized cells with a blastoid morphology resembling leukemic infiltration with sparing of epidermis and Grenz zone. | PDC | CD4+ CD56+ PDC-associated antigens+ (CD123, CD303, TCL1a, TCF4, CD2AP), TdT+/−, CD3−, MPO−, high Ki67 | Poor. CT+ allo-HSCT. High dose MTX+ asparaginase |
| DLBCL, leg-type | F:M = 3:1; often elderly | Solitary or clustered ulcerated plaques, papules, nodules; on legs (>80%) | Dense dermal and subcutaneous tissue infiltrate of large cells (centroblasts, immunoblasts); epidermotropism and angiotropism may be found. | Post-germinal center, mature B-lymphocytes | CD20+, CD79alpha+, Pax5+, TdT−, BCL6+/−, CD10−/+, MUM1/IRF4+, cyclin D1−, high Ki67 | Poor (40–50% 5-year survival); anthracycline-based CT+ rituximab |
| Plasmablastic MM | Adults | Solitary or generalized brown plaques or nodules. Skin involvement is often a late event in MM | Nodular; diffuse; or, less often, interstitial proliferation of neoplastic plasma cells with scarce cytoplasm and evident nucleolus, within deep dermis and subcutis with sparing of papillary dermis and epidermis | Plasma cells | CD138+, MUM1+, MUM18+, CD38+, CD20−/+, cyclin D1−/+, CD56+/−, CD79alpha+/− EBER-ISH-, high Ki67 | Poor; therapy tailored on systemic manifestations of MM |
| PBL | HIV+ young males or HIV- patients with other causes of IS | Solitary or multiple ulcerated nodules. Skin lesions may occur within a systemic PBL or as primary cutaneous PBL | Dermal and subcutaneous tissue infiltrate of atypical cells with plasmablastic, immunoblastic, or anaplastic features. | Post-germinal center B-lymphocytes | MUM1+, CD138+, EMA+, CD30+, CD20−, EBER-ISH+, HHV8−, high Ki67 | Poor despite CT |
Disclaimer/Publisher’s Note: The statements, opinions and data contained in all publications are solely those of the individual author(s) and contributor(s) and not of MDPI and/or the editor(s). MDPI and/or the editor(s) disclaim responsibility for any injury to people or property resulting from any ideas, methods, instructions or products referred to in the content. |
© 2023 by the authors. Licensee MDPI, Basel, Switzerland. This article is an open access article distributed under the terms and conditions of the Creative Commons Attribution (CC BY) license (https://creativecommons.org/licenses/by/4.0/).
Share and Cite
Zanelli, M.; Sanguedolce, F.; Zizzo, M.; Fragliasso, V.; Broggi, G.; Palicelli, A.; Loscocco, G.G.; Cresta, C.; Caprera, C.; Corsi, M.; et al. Skin Involvement by Hematological Neoplasms with Blastic Morphology: Lymphoblastic Lymphoma, Blastoid Variant of Mantle Cell Lymphoma and Differential Diagnoses. Cancers 2023, 15, 3928. https://doi.org/10.3390/cancers15153928
Zanelli M, Sanguedolce F, Zizzo M, Fragliasso V, Broggi G, Palicelli A, Loscocco GG, Cresta C, Caprera C, Corsi M, et al. Skin Involvement by Hematological Neoplasms with Blastic Morphology: Lymphoblastic Lymphoma, Blastoid Variant of Mantle Cell Lymphoma and Differential Diagnoses. Cancers. 2023; 15(15):3928. https://doi.org/10.3390/cancers15153928
Chicago/Turabian StyleZanelli, Magda, Francesca Sanguedolce, Maurizio Zizzo, Valentina Fragliasso, Giuseppe Broggi, Andrea Palicelli, Giuseppe Gaetano Loscocco, Camilla Cresta, Cecilia Caprera, Matteo Corsi, and et al. 2023. "Skin Involvement by Hematological Neoplasms with Blastic Morphology: Lymphoblastic Lymphoma, Blastoid Variant of Mantle Cell Lymphoma and Differential Diagnoses" Cancers 15, no. 15: 3928. https://doi.org/10.3390/cancers15153928
APA StyleZanelli, M., Sanguedolce, F., Zizzo, M., Fragliasso, V., Broggi, G., Palicelli, A., Loscocco, G. G., Cresta, C., Caprera, C., Corsi, M., Martino, G., Bisagni, A., Marchetti, M., Koufopoulos, N., Parente, P., Caltabiano, R., & Ascani, S. (2023). Skin Involvement by Hematological Neoplasms with Blastic Morphology: Lymphoblastic Lymphoma, Blastoid Variant of Mantle Cell Lymphoma and Differential Diagnoses. Cancers, 15(15), 3928. https://doi.org/10.3390/cancers15153928











